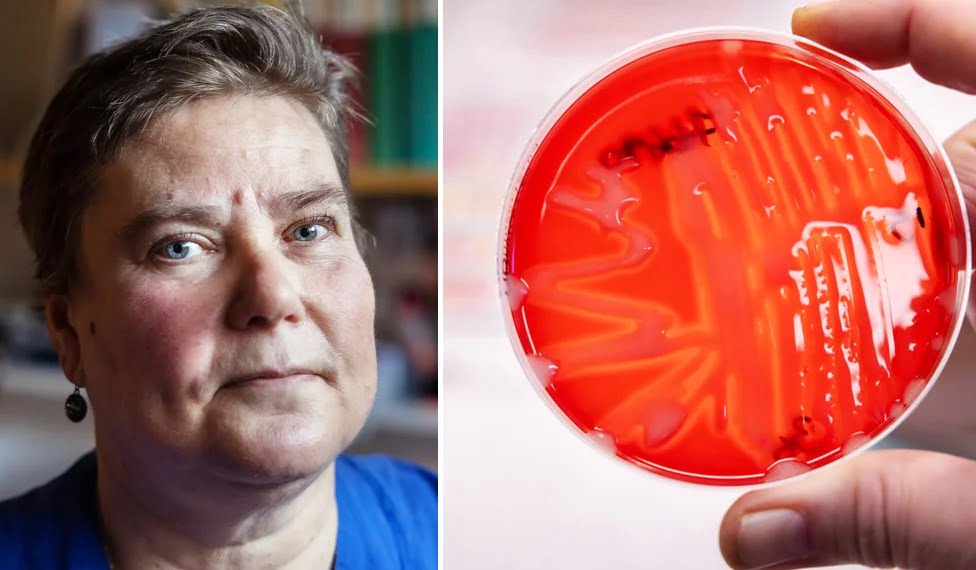

Under det gångna året har ett tjugotal läkare, sjuksköterskor och biologer börjat jobba på Sahlgrenska Universitetssjukhuset och Göteborgs universitet. En av dem är Mar Chernysh…
Inlägg publicerade i “Allmänt”
När den fullskaliga invasionen av Ukraina var ett faktum dröjde det inte länge förrän ST-läkaren Katja Blagodyr hade bokat en buss med förnödenheter till sina…
Första lastbilen med sjukvårdsmaterial från Västra Götalandsregionen gick redan dagen efter krigets utbrott. Sedan dess har över 40 transporter nått hälso-och sjukvården i olika städer…
I en källare på Klinisk mikrobiologi på Guldheden i Göteborg finns Sveriges absolut största bakteriesamling. Över 60 000 olika bakteriestammar ligger frystorkade och redo att…
Invånarna i nordöstra Göteborg har högre ohälsotal och kortare medellivslängd jämfört med andra stadsdelar. Ett sätt att förbättra den prognosen är genom motion. Men hur…
Ett sommarjobb kan vara början på något helt nytt – möjligheter att utvecklas, chansen till nya vänner eller kanske en ny väg i livet. Nu…
Under fredagseftermiddagen blev Västra Götalandsregionen (VGR) utsatt för en överbelastningsattack som resulterade i att flera externa webbtjänster – såsom 1177.se, vgregion.se och sjukhusens hemsidor –…
Gabriella Kalmar är formgivare på Västra Götalandsregionens kulturförvaltning. Nyligen fick hon ett annorlunda uppdrag: att illustrera mullvaden Mullward Grusnos, vars uppdrag är att leda barnen…
Västra Götalandsregionen (VGR) redovisar ett positivt resultat på 1 591 miljoner kronor för 2022. Det ger en nödvändig förstärkning av ekonomin inför tuffare tider. Året…
Hur svårt är det att åka skridsko på djurben? Vilka frågor vill du ställa till musikalartisterna på GöteborgsOperan? Och hur skrev man kärleksbrev på medeltiden?…